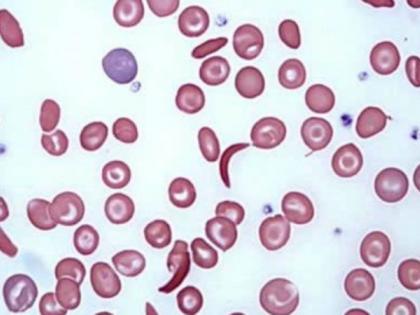

सिकलसेल : नवीन व खोट्या अस्पृश्यतेचा धोका!
By ऑनलाइन लोकमत | Updated: August 9, 2023 07:59 IST2023-08-09T07:57:23+5:302023-08-09T07:59:56+5:30
सिकलसेल हा रोग-जनुक असल्याचा ‘गैरसमज’ पसरला तर, अनुसूचित जाती-जमाती जनुकीय पुराव्याने निकृष्ट, सदोष ठरवल्या जातील..

सिकलसेल : नवीन व खोट्या अस्पृश्यतेचा धोका!
- डॉ. अभय बंग, माजी अध्यक्ष, आदिवासी आरोग्य तज्ज्ञ समिती, भारत सरकार
भारत सरकारने जुलैपासून सिकलसेल रोग निर्मूलनासाठी राष्ट्रीय मिशन सुरू केले आहे. या मिशनद्वारे सुरुवातीच्या तीन वर्षांत प्रामुख्याने आदिवासी भागातील सात कोटी लोकांची सिकलसेल तपासणी केली जाईल; परंतु अंतिमत: २७० जिल्ह्यांमधील ४० वर्षांहून कमी वयाच्या संपूर्ण लोकसंख्येची तपासणी केली जाईल आणि शेवटी, २०४७ पर्यंत हा रोग समूळ नष्ट करणे हे या मिशनचे उद्दिष्ट आहे.
सिकलसेल रोग असलेल्या लोकांना वैद्यकीय सेवा पुरवणे हे अतिशय स्वागतार्ह, योग्य आहे; परंतु कोट्यवधी लोकांच्या रक्त तपासणीचे प्रस्तावित धोरण व्यर्थ व धोकादायक ठरू शकते. ते धोरण प्रामुख्याने अनुसूचित जमाती (ST) आणि अनुसूचित जाती (SC) लोकसंख्येला लक्ष्य करेल, कारण सिकल जीन प्रामुख्याने त्यांच्यामध्ये आढळतात. माननीय आरोग्यमंत्री म्हणाले की, १० % आदिवासी लोकसंख्येला सिकलसेल गुण (ट्रेट) आहे आणि १% लोकांना हा आजार आहे. सिकलसेल हे एक अनुवांशिक वैशिष्ट्य आहे. ज्यामध्ये काही लाल रक्तपेशी सिकल किंवा विळ्याचा आकार घेतात. तो स्वतः एक आजार नाही. सिकल दोन स्वरूपात पालकांकडून मुलांना मिळतो. फक्त एका पालकाकडून सिकल जनुक मिळाला तर, संततीला सिकलसेल ट्रेट किंवा वाहक म्हणतात. वाहकावर कोणताही हानिकारक परिणाम होत नाही. पण सिकलसेल वाहकाने दुसऱ्या सिकलसेल वाहकाशी लग्न केले तर त्यांच्या चारपैकी एका संततीला सिकलसेलचा दुहेरी डोस (होमोझायगस) मिळून गंभीर रोग होऊ शकतो. अशा व्यक्तीला अनेक वैद्यकीय समस्या असू शकतात आणि कमी वयात त्या व्यक्तीचा मृत्यू होऊ शकतो. मात्र, यातही काही तारणहार आहेत. प्रथम, होमोझायगस व्यक्ती जन्माला येण्याची शक्यता फारच कमी आहे. आदिवासी लोकांपैकी फक्त एक टक्के लोक सिकल होमोझायगस आहेत. दुसरे, भारतातील सिकलसेल रोगाची तीव्रता कमी आहे.
सिकल नावाचा जनुक आफ्रिका, भूमध्यसागरीय देश, मध्यपूर्व आणि भारतात इतका व्यापक का पसरला? ऐतिहासिकदृष्ट्या या सर्व भागांत मलेरियाचा प्रादुर्भाव होता. अंदाजे ७,००० किंवा ४०,००० वर्षांपूर्वी, सिकल जीन आफ्रिकेत अचानक म्युटंट म्हणून उदयास आला. रक्तातील सिकल हिमोग्लोबिनमुळे मलेरियापासून संरक्षण मिळते. सिकल म्यूटंट असलेले लोक जगले आणि या सर्व प्रदेशांमध्ये पसरले. मलेरियाच्या प्रभावी नियंत्रणानंतर सिकलद्वारे मिळणाऱ्या संरक्षणाची उपयुक्तता संपेल. पण, जनुक कायम राहील. शिवाय, आफ्रिका आणि भारतातील आदिवासी भागांत मलेरिया अजूनही एक मोठी समस्या आहे.
अशा प्रकारे, सिकलसेल हा आजार नसून नैसर्गिक संरक्षण आहे. क्वचितच हा एक आजार आहे व तो भारतात बरेचदा सौम्य असतो. सिकलसेल हा रोग-जनुक आहे, असा समज पसरवणे हानिकारक ठरेल. शिवाय, जगण्याचा फायदा देणारे जनुक काढून टाकणे अशक्य आहे. म्हणूनच भारत सरकारने विचारपूर्वक त्याला ‘सिकलसेल ॲनिमिया निर्मूलन मिशन’ असे नाव दिले. रोग थांबवायचा आहे, सिकल जीन नाही. तथापि यासाठी सिकलसेल जनुकाचे लपलेले वाहक शोधण्यासाठी लोकसंख्येची आक्रमक तपासणी करणे, त्यांना ओळखपत्र देणे, त्यांची राष्ट्रीय नोंदणी करणे आणि त्यांना दुसऱ्या सिकलसेलशी लग्न न करण्याचा सल्ला देणे या प्रस्तावित कार्यक्रमाचे दोन संभाव्य परिणाम आहेत. एक अपयश आणि दुसरी आपत्ती. या मोहिमेमुळे सिकलसेल स्थितीला कलंक लागण्याची शक्यता आहे. त्यामुळे वाहकांच्या विवाहामध्ये अडथळा येऊ शकतो. मी एका महिला डॉक्टरला ओळखतो. जी थॅलेसेमियाची (सिकलसारखा आजार) वाहक आहे. ती दुसऱ्या वाहकाशिवाय कोणाशीही सुरक्षितपणे लग्न करू शकते. तथापि, कोणीही धोका पत्करू इच्छित नाही. कुटुंबात ‘रोगाचे’ जीन्स का आणायचे? - म्हणून दहा वर्षांनंतरही ती डॉक्टर अविवाहित आहे.
या अडथळ्यामुळे, सिकल वाहक म्हणून निदान झालेल्या तरुण व्यक्ती लग्नाच्या वेळी ही वस्तुस्थिती लपवून ठेवतील. चांगला वैवाहिक जोडीदार गमावण्यापेक्षा भविष्यात आजारी मूल होण्याचा किंचित धोका पत्करणे चांगले आहे, असा विचार वाहक करेल. त्यामुळे तपासणीचा उद्देशच असफल होईल. जगप्रसिद्ध सिकलसेल शास्त्रज्ञ डॉ. सार्जेंट यांनी २०१७ मध्ये, ‘जमैकामध्ये सिकलसेल रोग रोखण्यासाठी रक्त तपासणी : ते परिणामकारक ठरते का?’ शीर्षकाचा पेपर प्रकाशित केला. त्यांचा निष्कर्ष आहे - नाही !

तथापि, आणखी एक धोका आहे. भारतात वर्ण आणि जाती रचना खोलवर रुजली आहे. परिणामी, लोकसंख्येचा एक मोठा भाग जवळजवळ दोन हजार वर्षे वंचित व बहिष्कृत राहिला. दुर्दैवाने, त्याच जाती, दलित व आदिवासींमध्ये, सिकल जनुकाचे प्रमाण जास्त आहे. सिकलबाबत या जातींच्या व्यापक तपासणी मोहिमेमुळे समाजात असा गैरसमज मूळ धरू शकतो की, सिकल जनुक हा एक दोष आहे, आणि तो आदिवासी व दलितांमधे असल्याने या जाती जनुकीय आधारावर निकृष्ट आहेत. आत्तापर्यंत ते सामाजिक किंवा धार्मिक आधारावर ‘खालचे’ मानले जात होते. आता सिकलचा जनुकीय पुरावा वापरला जाईल की ते निकृष्ट, सदोष आहेत आणि त्यांना लग्न संबंधात वगळले पाहिजे... ती किती मोठी सामाजिक आपत्ती असेल!
मला एक सुधारित रणनीती सुचवू द्या.
एक : माहिती मोहिमेत सिकल जीनला निसर्गाची देणगी म्हणून साजरा करा, त्याला रोग म्हणून रंगवू नका.
दोन : आजार असलेल्या लोकांना उपचार आणि मदतीची व्यवस्था करा.
तीन : लोकसंख्या तपासणीच्या धोरणाबाबत पुनर्विचार करा. ते निरर्थक किंवा घातक ठरू शकते.
- search.gad@gmail.com